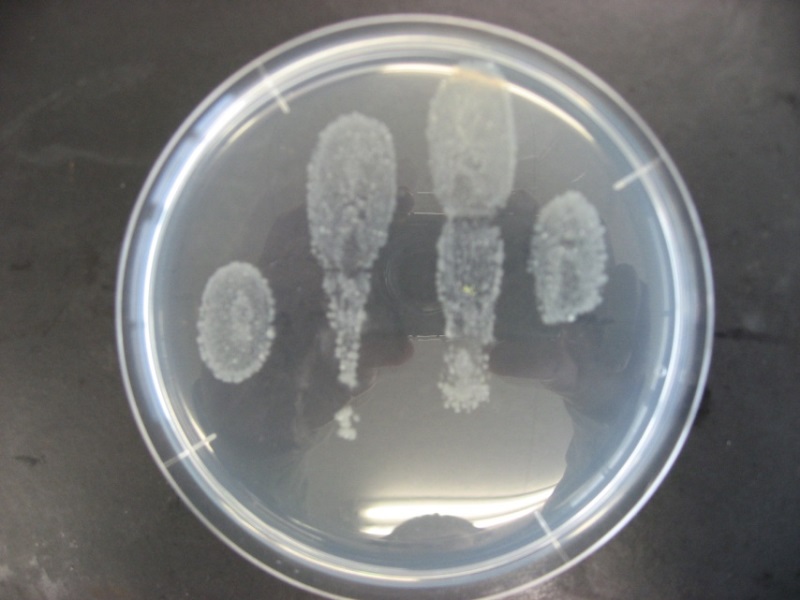
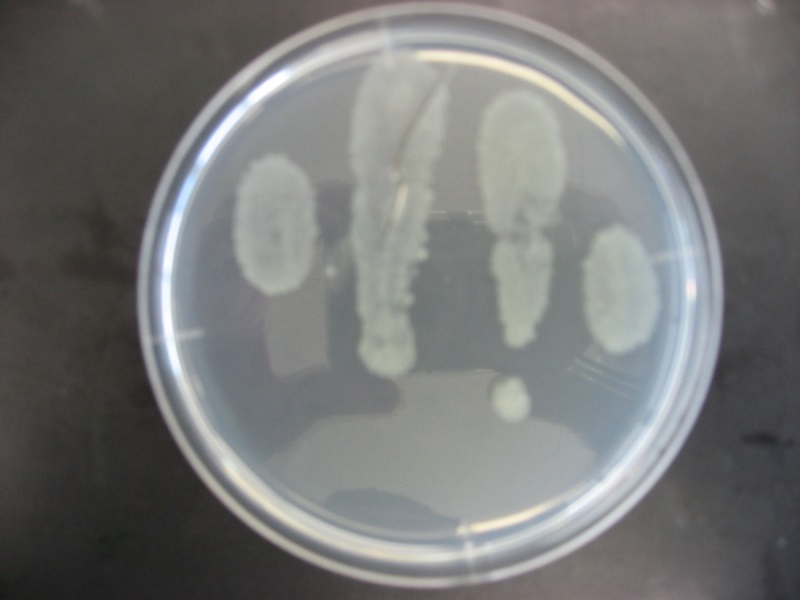

除菌と潤滑が同時にできるスプレー
①はさみの動きが軽くバリカンの動きも良くなる
②アルコール80%含有で強力除菌
③乾きが早くべたつかない
④器具についた毛を吹き飛ばしていつでも清潔
⑤サロンにそのまま置けるシンプルなデザイン
⑥420mlの大容量でとってもお得
成分 | アルコール、潤滑剤、LPG |
---|---|
液性 | 中性 |
荷姿 | 420mlエアゾール缶 |
用途
ハサミ、バリカンの除菌、潤滑、洗浄
除菌できる潤滑スプレーの使用方法
2WAYキャップ(キャップは外さず噴射OK)
● ノズルを使用するとピンポイントで、ノズルを収納すると広範囲にスプレーできます。
● 布・ティッシュに吹きかけ、拭き取り洗浄もできます。

ノズルをたたんでワイド噴射

ノズルをたててピンポイント噴射
除菌できる潤滑スプレーの特長
除菌できる潤滑スプレーの技術資料
消毒試験
<方法>
使い古したスポンジを握った後、①除菌できる潤滑スプレーで殺菌 ②消毒エタノールで殺菌 ③そのまま生菌数測定寒天培地に手を左右それぞれ5秒間押し付けて、29℃の培養器に1日間入れて菌が発生するかどうか確認した。
<結果>
③消毒なしでは様々な菌が数えられないほど発生していた。一方で、①除菌できる潤滑スプレー②消毒エタノールで消毒したものは白い菌しかなく、数えられる程度しか出ていなかった。このことから除菌できる潤滑スプレーは消毒エタノールとほぼ同等の消毒効果があると考えられる。
消毒試験の写真
除菌できる潤滑スプレー


消毒エタノール


消毒なし

除菌できる潤滑スプレーの使用事例
事例① バリカン
・除菌
・潤滑
・防錆
・洗浄
・冷却
使用前に一吹きすれば、除菌(清潔)だけでなく
切れやすくなります(音が変わります)
特徴・注意事項
・細かい髪の毛を強力噴射で取り除きます。
(いっぱい詰まった髪の毛を噴射だけで取り除くのは難しいです。こまめにお掃除を!)
冷却効果で熱くなった刃先を冷却できます。
・噴射する時はバリカンの電源を必ず切って下さい。噴射後しばらく放置し、乾燥させてから電源を入れて下さい。
(引火性があるので、通電している電気製品に使用すると、火花・静電気で発火することがあります。)
事例② ハサミ
・除菌
・潤滑
・防錆
・洗浄

除菌中

ハサミの動きが軽くなります。
特徴・注意事項
・ティッシュの上にハサミを置き、ネジ部はノズルを立てて潤滑、刃部はノズルをたたんで除菌できます。使用後拭き取って下さい。
・ハサミが軽くなりすぎの場合には、ネジ部の使用頻度を控えて下さい。
・オイルのいらないハサミには、刃部の除菌のみ行って下さい。
事例③ コーム・ブラシ
・除菌
・洗浄
・極薄被膜
ベタツキがなく、髪につくこともありません
特徴・注意事項
・コーム・ブラシに付いた汚れを洗浄・除菌します。噴射後、布等で拭き取って下さい。
・きつい汚れは噴射だけで取れない可能性があります。
使用状の注意点
用途以外に使用しない事。革製品、塗料製品、木材等でシミになる恐れがあります。
スタイリスト様からよくあるご質問 Q&A
項目 | Q | A |
---|---|---|
除菌 | 除菌効果は十分ありますか? | アルコール80%なので、消毒用アルコールと同等の除菌効果があります。 |
理美容器具全般に使用できますか? | 使用可能です。しかし、カミソリはアルコールに漬け置き消毒が必要なので使用できません。 | |
潤滑 | 潤滑成分はどんなものですか? | 化粧品で使用されるアルコール系ポリマー剤が、ベタツキのない極薄被膜(0.1μm以下)を形成します。 |
お客様毎に使用しても大丈夫ですか? | 連続使用でも皮膜は重ならず、使用毎に新しい皮膜になるため、問題ありません。 | |
潤滑の効果はどのくらいもちますか? | 使用頻度にもよりますが、1日~1週間の期間 潤滑効果があります。 | |
防錆 | バリカンの刃が錆びることはないですか? | 高い防錆力がありますので、サビの心配はありません。 |
その他 | 何回位使えますか? | 約0.5秒の噴射で777回使用できます。1回の噴射が約3円になります。 |
どのタイミングで使用すれば良いですか? | お客様が変わる毎を推奨しますが、出来ない時は仕事終わりに除菌・潤滑して下さい。 | |
ノズルはどうやって使用すれば良いですか? | 全体を除菌する時(ハサミ刃部、バリカン、コーム等)はノズルをたたんで、ピンポイントに潤滑・洗浄する時(ハサミネジ部、掃除時)はノズルを立ててお使いください。 | |
使用出来ない材質はありますか? | シミになるような革製品、木材はお避け下さい。 | |
使用時の注意事項はありますか? | オイルのいらないハサミには、刃部の除菌・洗浄のみ行ってください。また、バリカンは必ず電源を切ってお使いください。使用後は、しばらく放置して乾燥させてから電源を入れてください。 |
除 菌 | 除菌効果は十分ありますか? |
---|---|
アルコール80%なので、消毒用アルコールと同等の除菌効果があります。 | |
理美容器具全般に使用できますか? | |
使用可能です。しかし、カミソリはアルコールに漬け置き消毒が必要なので使用できません。 | |
潤 滑 | 潤滑成分はどんなものですか? |
化粧品で使用されるアルコール系ポリマー剤が、ベタツキのない極薄被膜(0.1μm以下)を形成します。 | |
お客様毎に使用しても大丈夫ですか? | |
連続使用でも皮膜は重ならず、使用毎に新しい皮膜になるため、問題ありません。 | |
潤滑の効果はどのくらいもちますか? | |
使用頻度にもよりますが、1日~1週間の期間 潤滑効果があります。 | |
防 錆 | バリカンの刃が錆びることはないですか? |
高い防錆力がありますので、サビの心配はありません。 | |
そ の 他 | 何回位使えますか? |
約0.5秒の噴射で777回使用できます。1回の噴射が約3円になります。 | |
どのタイミングで使用すれば良いですか? | |
お客様が変わる毎を推奨しますが、出来ない時は仕事終わりに除菌・潤滑して下さい。 | |
ノズルはどうやって使用すれば良いですか? | |
全体を除菌する時(ハサミ刃部、バリカン、コーム等)はノズルをたたんで、ピンポイントに潤滑・洗浄する時(ハサミネジ部、掃除時)はノズルを立ててお使いください。 | |
使用出来ない材質はありますか? | |
シミになるような革製品、木材はお避け下さい。 | |
使用時の注意事項はありますか? | |
オイルのいらないハサミには、刃部の除菌・洗浄のみ行ってください。また、バリカンは必ず電源を切ってお使いください。使用後は、しばらく放置して乾燥させてから電源を入れてください。 |